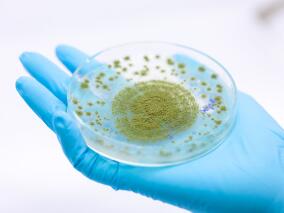
甲氧西林敏感金黄色葡萄球菌菌血症：氯唑西林+磷霉素vs仅氯唑西林
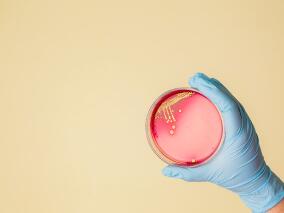
复杂金黄色葡萄球菌菌血症：头孢比罗酯pk达托霉素

-
预防成人ICU感染:碘伏-CHG vs莫匹罗星-CHG
环球医学资讯
2023年10月31日
点击量:378
1小时条评论在重症监护室(ICU)中,通用鼻腔莫匹罗星+葡萄糖酸氯己定(CHG)浴,可预防耐甲氧西林金黄色葡萄球菌(MRSA)感染和全因血流感染。对莫匹罗星的抗生素耐药已经引发了人们对消毒剂是否在ICU去定植中具有优势提出了疑问。2023年10月,发表在《JAMA》的一项随机临床试...
-
预防儿童复发性呼吸道感染 复方益生菌大显神通
环球医学资讯
2023年10月31日
点击量:206
1小时条评论多菌种益生菌在预防儿童复发性呼吸道感染的严重程度和频率中的作用未知。2023年10月,发表在《BMC Pediatr》的一项研究显示,服用复方益生菌可以减少儿童复发性呼吸道感染。 背景:呼吸道感染是全球儿科人群中最常见的感染之一。全球范围内,5岁以下儿童死亡人数中...
-
撒哈拉以南非洲的HIV感染合并糖尿病患者 二甲双胍安全
环球医学资讯
2023年10月31日
点击量:327
1小时条评论二甲双胍预防在撒哈拉以南非洲(SSA)的HIV合并2型糖尿病患者中的疗效未知。2023年10月,发表在《Diabetologia》的一项研究显示,二甲双胍治疗对HIV合并糖尿病前期患者是安全的。 目的/假设:在SSA,5%的成人患有2型糖尿病,并且这一数字正在急剧上升,在HIV感染者...
-
吸入式糠酸氟替卡松用于新冠门诊治疗 有效性如何?
环球医学资讯
2023年10月26日
点击量:209
1小时条评论预防新冠肺炎进展为严重疾病的早期治疗需求仍在持续。2023年9月,美国学者发表在《N Engl J Med》的一项研究,考察了吸入式糠酸氟替卡松用于新冠门诊治疗的有效性。 背景:吸入性糖皮质激素在缩短轻度至中度新冠门诊患者症状缓解时间或预防住院或死亡方面的有效性尚...
-
甲氧西林敏感金黄色葡萄球菌菌血症:氯唑西林+磷霉…
环球医学资讯
2023年10月26日
点击量:522
1小时条评论金黄色葡萄球菌是危及生命的社区获得性和医疗保健相关菌血症的主要原因。2023年10月,西班牙学者发表在《Nat Med》的一项随机试验,考察了氯唑西林+磷霉素vs仅氯唑西林治疗甲氧西林敏感(MSSA)金黄色葡萄球菌菌血症的效果。 约25%的MSSA菌血症患者出现治疗失败。本...
-
复杂金黄色葡萄球菌菌血症:头孢比罗酯pk达托霉素
环球医学资讯
2023年10月26日
点击量:272
1小时条评论金黄色葡萄球菌菌血症常见且通常致命。2023年10月,美国、乌克兰、德国等国学者发表在《N Engl J Med》的一项研究,考察了头孢比罗酯治疗复杂金黄色葡萄球菌菌血症的效果。 背景:头孢比罗酯是一种头孢菌素,可有效治疗复杂金黄色葡萄球菌菌血症,包括耐甲氧西林金...
-
镰状细胞性贫血患儿预防感染 补锌有用吗?
环球医学资讯
2023年10月25日
点击量:147
1小时条评论锌对于镰状细胞性贫血患儿感染的预防效果如何呢?2023年7月,发表在《Blood Adv》一项随机双盲安慰剂对照试验,可供参考一二。 来自美国和印度小型临床试验的数据表明,补充锌可以减少镰状细胞性贫血(SCA)青少年和成人的感染,但尚未对生活在非洲的SCA儿童进...
-
随机接受抗生素治疗的说英语和说西语的阑尾炎患者 …
环球医学资讯
2023年10月23日
点击量:192
1小时条评论在美国,2500万人(占总人口的8.4%)的英语能力有限。西班牙语是美国家庭中第二常见语言,40%的西班牙语使用者英语能力有限。2023年9月,美国学者发表在《JAMA Surg》的CODA随机临床试验的二次分析,考察了随机接受抗生素治疗的说英语和说西班牙语的阑尾炎患者的试验...
-
预防中央导管相关血流感染 这篇文章说清楚了
环球医学资讯
2023年10月19日
点击量:354
1小时条评论2023年9月,发表在《N Engl J Med》的一篇综述,详细概述了中央导管相关血流感染(CLBSI)的发病机制,风险因素,行之有效的预防策略和设备。 许多内科和外科疾病的管理通常包括长期输注静脉液体、广谱抗生素、癌症化学治疗剂、重症监护治疗、居家抗生素给药、全肠...
-
莫诺拉韦对非重症新冠的有效性
环球医学资讯
2023年10月19日
点击量:172
1小时条评论莫诺拉韦治疗非重症COVID-19的有效性未知。2023年9月,发表在《J Antimicrob Chemother》的一项Meta分析显示,该方案有效,但有效性因年龄和性别而异。 背景:莫诺拉韦是新冠的一种有前景的候选药物,但需要进一步评估其在非重症新冠患者中的有效性和安全性以及在具...

会员登录

